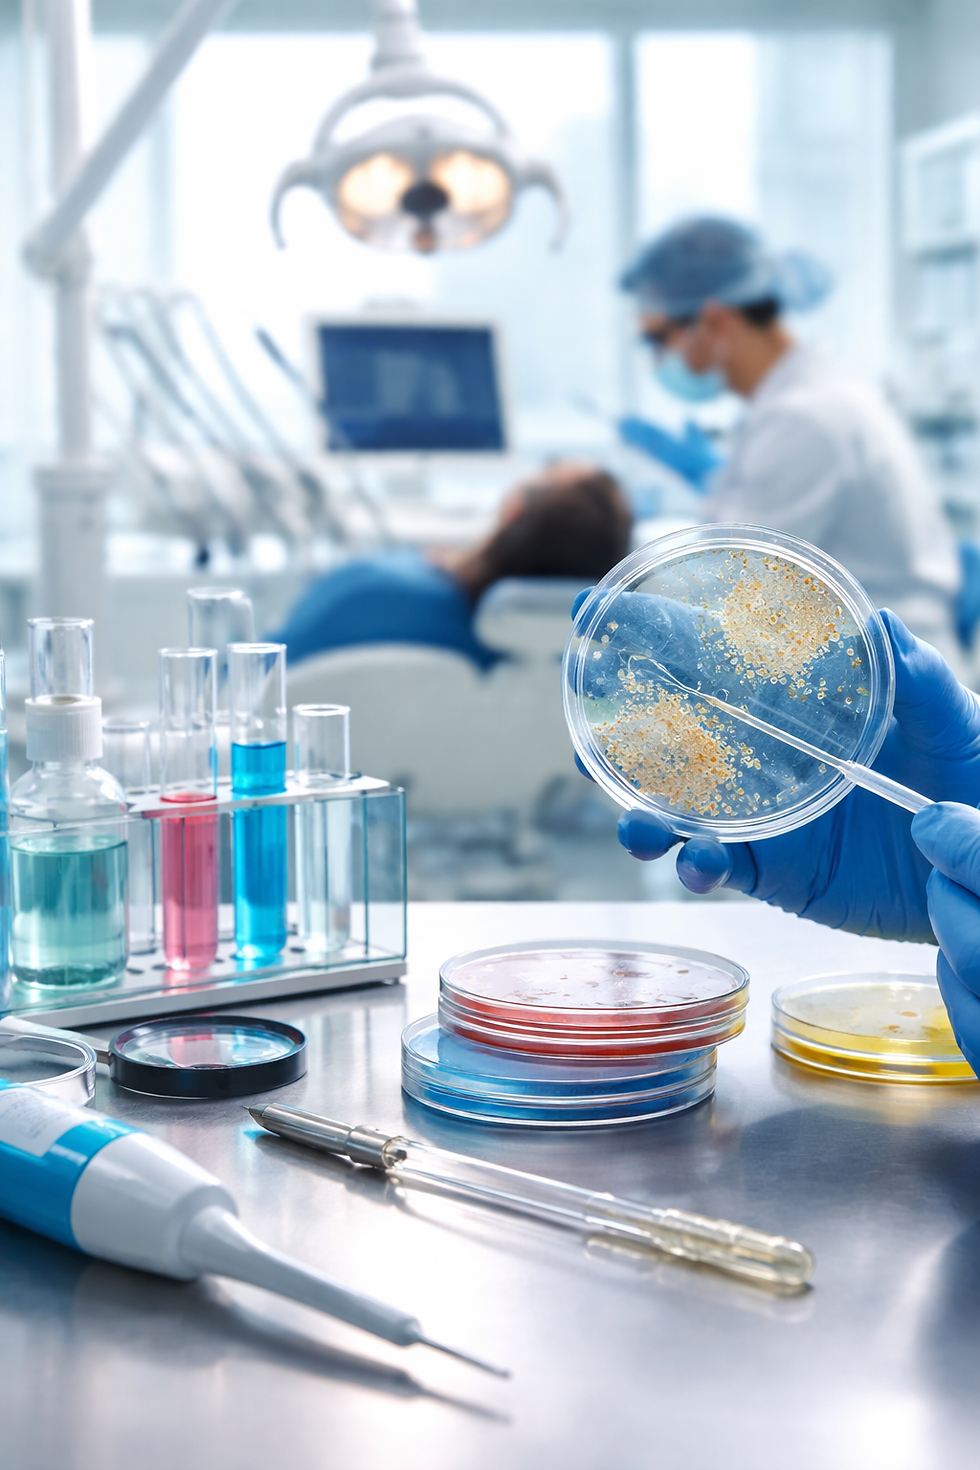

Controle Microbiológico em Clínicas Odontológicas: Fundamentos Científicos, Normativos e Estratégias de Monitoramento.
- Keller Dantara
- 8 de fev.
- 7 min de leitura
Introdução
A prática odontológica contemporânea está intrinsecamente associada a um conjunto de procedimentos invasivos que envolvem contato direto com mucosas, sangue, saliva e aerossóis potencialmente contaminados. Nesse cenário, o controle microbiológico em clínicas odontológicas não se limita a uma exigência regulatória: trata-se de um componente central da segurança do paciente, da proteção ocupacional das equipes de saúde e da credibilidade institucional dos serviços prestados.
A cavidade oral abriga uma microbiota complexa, composta por centenas de espécies bacterianas, além de fungos e vírus que podem atuar como agentes oportunistas ou patogênicos. Procedimentos como raspagens periodontais, cirurgias, restaurações com alta rotação e uso de ultrassom geram aerossóis capazes de dispersar microrganismos no ambiente clínico. Estudos publicados no Journal of Dental Research e no Clinical Oral Investigations demonstram que esses aerossóis podem permanecer suspensos por períodos variáveis, depositando-se em superfícies, instrumentais e sistemas de água das unidades odontológicas.
Além disso, o aumento da complexidade assistencial — incluindo atendimento a pacientes imunossuprimidos, idosos e indivíduos com comorbidades — eleva o grau de responsabilidade técnica das clínicas. O controle microbiológico passa, portanto, a integrar uma abordagem sistêmica que envolve biossegurança, monitoramento ambiental, validação de processos de esterilização, qualidade da água utilizada em equipamentos e rastreabilidade de protocolos.
Este artigo examina o controle microbiológico em clínicas odontológicas sob uma perspectiva histórica, normativa e técnico-científica. Serão discutidos os fundamentos teóricos da microbiologia aplicada à prática odontológica, os principais marcos regulatórios nacionais e internacionais, as implicações científicas e operacionais do controle ambiental e de superfícies, bem como as metodologias analíticas empregadas no monitoramento microbiológico. Por fim, serão apresentadas considerações sobre tendências futuras, inovação tecnológica e fortalecimento institucional das práticas de biossegurança.
Contexto Histórico e Fundamentos Teóricos
Evolução Histórica do Controle de Infecções na Odontologia
O controle microbiológico em ambientes de saúde tem raízes no século XIX, com os trabalhos de Ignaz Semmelweis e Louis Pasteur, que estabeleceram as bases da teoria germinal das doenças. No campo odontológico, a consolidação de práticas de assepsia e esterilização ocorreu de forma mais tardia, acompanhando o desenvolvimento dos equipamentos rotatórios e o avanço da cirurgia bucomaxilofacial.
Nas décadas de 1970 e 1980, a epidemia de HIV/AIDS transformou radicalmente os protocolos de biossegurança. A partir desse período, consolidou-se o conceito de “precauções universais”, posteriormente substituído pelo termo “precauções padrão”, incorporado às diretrizes do Centers for Disease Control and Prevention (CDC). O documento “Guidelines for Infection Control in Dental Health-Care Settings”, publicado pelo CDC em 2003 e atualizado em 2016, tornou-se referência internacional para práticas de controle de infecção em odontologia.
No Brasil, a Agência Nacional de Vigilância Sanitária (ANVISA) estabeleceu normas importantes, como a RDC nº 15/2012, que dispõe sobre requisitos de boas práticas para o processamento de produtos para saúde, e a RDC nº 63/2011, que trata de boas práticas de funcionamento para serviços de saúde. Essas normativas estruturam a responsabilidade técnica das clínicas odontológicas no que diz respeito à esterilização, armazenamento e rastreabilidade de instrumentais.
Microbiologia Aplicada ao Ambiente Odontológico
O ambiente odontológico é classificado como área crítica ou semicrítica, dependendo do tipo de procedimento realizado. Instrumentais que penetram tecidos moles ou ósseos são considerados críticos e devem ser esterilizados; aqueles que entram em contato com mucosas, mas não penetram tecidos, são semicríticos e requerem desinfecção de alto nível ou esterilização.
Os principais microrganismos de interesse incluem:
Staphylococcus aureus (incluindo cepas resistentes como MRSA)
Pseudomonas aeruginosa
Enterobactérias
Fungos do gênero Candida
Vírus como HBV, HCV e SARS-CoV-2
A presença desses microrganismos pode ocorrer por contato direto, aerossóis ou falhas em processos de limpeza e desinfecção. Estudos indicam que biofilmes podem se formar nas linhas de água das cadeiras odontológicas, especialmente quando não há protocolos regulares de desinfecção química. Esses biofilmes representam reservatórios microbianos persistentes, com potencial de liberação contínua de bactérias na água utilizada durante os procedimentos.
Marcos Normativos e Regulamentares
O arcabouço regulatório do controle microbiológico em odontologia inclui:
Diretrizes do CDC (EUA)
Normas da Organização Mundial da Saúde (OMS)
RDC nº 15/2012 e RDC nº 63/2011 (ANVISA)
Normas ISO relacionadas à esterilização (ISO 11135, ISO 17665)
Recomendações da American Dental Association (ADA)
No contexto brasileiro, as vigilâncias sanitárias estaduais e municipais também exercem papel fiscalizador, exigindo registros de monitoramento microbiológico e validação periódica de autoclaves por meio de indicadores biológicos e químicos.
Esses marcos normativos refletem a transição de um modelo reativo — focado apenas na ocorrência de infecções — para um modelo preventivo e baseado em gestão de risco.
Importância Científica e Aplicações Práticas
Impactos na Segurança do Paciente
A literatura científica aponta que infecções associadas à assistência à saúde (IRAS) podem ocorrer também em ambientes odontológicos, embora com menor frequência quando comparadas a hospitais. Entretanto, a subnotificação é um desafio recorrente.
Estudos conduzidos na Europa indicam que a contaminação de superfícies próximas à cadeira odontológica pode ultrapassar 10³ UFC/cm² após procedimentos geradores de aerossol, caso não haja barreiras físicas e protocolos rigorosos de desinfecção. Esse dado reforça a importância do monitoramento ambiental periódico.
A implementação de protocolos robustos de controle microbiológico contribui para:
Redução do risco de transmissão cruzada
Proteção ocupacional das equipes
Melhoria da imagem institucional
Conformidade regulatória
Monitoramento da Qualidade da Água
A água utilizada nas unidades odontológicas deve atender a padrões microbiológicos específicos. O CDC recomenda que a contagem bacteriana heterotrófica não ultrapasse 500 UFC/mL, valor semelhante ao recomendado para água potável pela Environmental Protection Agency (EPA).
No Brasil, a Portaria GM/MS nº 888/2021 estabelece padrões de potabilidade da água. Embora voltada ao abastecimento público, seus parâmetros são frequentemente utilizados como referência para avaliação da qualidade da água em clínicas.
Casos documentados de infecção por Mycobacterium abscessus associados a sistemas de água contaminados evidenciam a relevância do controle de biofilmes nas linhas de água odontológicas.
Estudos de Caso Institucionais
Instituições universitárias que implementaram programas sistemáticos de monitoramento microbiológico relataram redução significativa de não conformidades sanitárias. Em um estudo publicado na American Journal of Infection Control, clínicas-escola que adotaram auditorias trimestrais de superfícies e sistemas de esterilização apresentaram aumento de 35% na conformidade com protocolos internacionais.
Esses resultados demonstram que o controle microbiológico não é apenas uma exigência regulatória, mas um diferencial competitivo e acadêmico.
Metodologias de Análise
Monitoramento de Superfícies
A avaliação microbiológica de superfícies pode ser realizada por meio de:
Swab estéril com cultura em ágar padrão
Placas de contato (RODAC)
Testes rápidos de ATP (bioluminescência)
Embora o teste de ATP forneça resultado rápido, ele mede matéria orgânica total e não distingue microrganismos viáveis de resíduos inertes. Por isso, culturas microbiológicas continuam sendo o padrão-ouro para avaliação quantitativa.
Controle de Esterilização
A validação de autoclaves envolve:
Indicadores químicos (classes 1 a 6, conforme ISO 11140)
Indicadores biológicos contendo esporos de Geobacillus stearothermophilus
Teste Bowie-Dick para verificação de remoção de ar
Esses métodos garantem que parâmetros críticos — temperatura, pressão e tempo — tenham sido adequadamente atingidos.
Análise da Água
As metodologias incluem:
Contagem padrão em placa (HPC)
Filtração por membrana
Identificação por métodos bioquímicos ou espectrometria de massa (MALDI-TOF)
Normas da APHA, descritas no Standard Methods for the Examination of Water and Wastewater (SMWW), são amplamente utilizadas como referência técnica.
Limitações e Avanços
Limitações incluem variabilidade na coleta, interferência ambiental e necessidade de infraestrutura laboratorial. Em contrapartida, tecnologias como PCR em tempo real e sequenciamento genético ampliam a capacidade de detecção de patógenos específicos, reduzindo o tempo de resposta.
Considerações Finais e Perspectivas Futuras
O controle microbiológico em clínicas odontológicas representa um eixo estruturante da biossegurança contemporânea. Sua relevância ultrapassa o cumprimento normativo, integrando-se a uma cultura institucional de prevenção, responsabilidade técnica e compromisso com a saúde coletiva.
A tendência futura aponta para maior incorporação de tecnologias digitais de monitoramento, rastreabilidade automatizada de ciclos de esterilização e integração de dados microbiológicos em sistemas de gestão da qualidade. A ampliação do uso de métodos moleculares e sensores inteligentes pode permitir diagnósticos ambientais quase em tempo real.
Instituições que investem em capacitação contínua, auditorias internas e validação científica de seus processos tendem a alcançar níveis mais elevados de excelência operacional. Em um contexto de crescente exigência regulatória e conscientização pública, o controle microbiológico consolida-se como elemento essencial para a sustentabilidade técnica e ética das clínicas odontológicas.
A consolidação de parcerias entre clínicas, laboratórios e centros de pesquisa poderá impulsionar novas investigações sobre aerossóis, biofilmes e resistência microbiana, fortalecendo a interface entre prática clínica e produção científica. Dessa forma, o controle microbiológico deixa de ser apenas uma exigência sanitária e passa a ocupar posição estratégica na evolução da odontologia baseada em evidências.
A Importância de Escolher a Polaris Análises
Com anos de experiência no mercado, a Polaris Análises possui um histórico comprovado de sucesso em análises laboratoriais.
Empresas do setor alimentício, indústrias farmacêuticas, laboratórios e outros segmentos confiam na Polaris Análises para garantir a segurança e qualidade da água utilizada em suas atividades.
Evitar riscos de contaminação é um compromisso com a saúde de seus clientes e com a longevidade do seu negócio. Investir em análises periódicas é um diferencial que fortalece sua reputação e evita prejuízos futuros.
Para saber mais sobre os serviços da Polaris Análises - Análises de Ar, Água, Alimentos, Swab e Efluentes ligue para (11) 91776-7012 (WhatsApp) ou clique aqui e solicite seu orçamento.
❓ FAQs – Perguntas Frequentes
1. O que envolve o controle microbiológico em clínicas odontológicas?
O controle microbiológico envolve um conjunto de práticas destinadas a prevenir, monitorar e reduzir a presença de microrganismos patogênicos no ambiente clínico. Isso inclui a esterilização de instrumentais, desinfecção de superfícies, monitoramento da qualidade da água das unidades odontológicas, controle de aerossóis e validação periódica dos processos de biossegurança.
2. Por que o controle microbiológico é essencial na odontologia?
Procedimentos odontológicos frequentemente geram aerossóis e envolvem contato com sangue e saliva, aumentando o risco de transmissão cruzada. Um controle microbiológico rigoroso protege pacientes e profissionais, reduz infecções associadas à assistência à saúde (IRAS) e assegura conformidade com normas sanitárias nacionais e internacionais.
3. Quais microrganismos representam maior preocupação em clínicas odontológicas?
Entre os principais estão Staphylococcus aureus, Pseudomonas aeruginosa, enterobactérias, fungos do gênero Candida e vírus como hepatites B e C. Além disso, a formação de biofilmes nas linhas de água das cadeiras odontológicas pode favorecer a proliferação de bactérias oportunistas.
4. Como é realizado o monitoramento microbiológico de superfícies e equipamentos?
O monitoramento pode ser feito por meio de swabs com cultura microbiológica, placas de contato (RODAC), testes de bioluminescência por ATP e indicadores biológicos para validação de autoclaves. Esses métodos permitem avaliar a eficácia dos protocolos de limpeza, desinfecção e esterilização.
5. A água utilizada nas cadeiras odontológicas precisa de controle específico?
Sim. A água deve atender a padrões microbiológicos compatíveis com água potável, com limites recomendados de contagem bacteriana heterotrófica. A manutenção adequada das linhas de água e o controle de biofilmes são fundamentais para evitar contaminações persistentes.
6. O monitoramento microbiológico pode prevenir não conformidades sanitárias?
Sim. Programas estruturados de controle microbiológico permitem identificar falhas precocemente, validar processos de esterilização, ajustar protocolos de higienização e reduzir riscos regulatórios, fortalecendo a segurança assistencial e a reputação institucional da clínica.
_edited.png)



Comentários